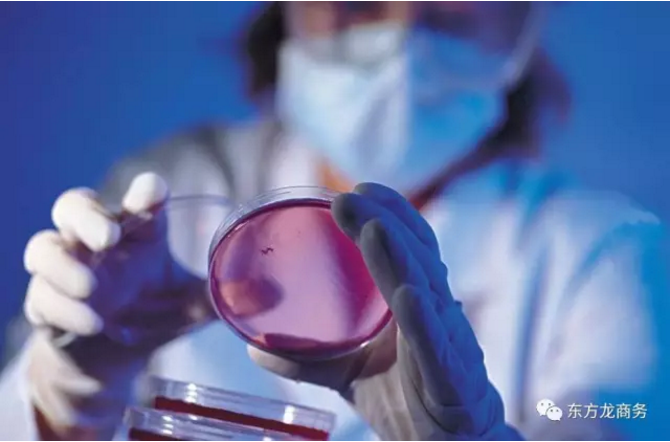

NEWS CENTER

東方龍商務將于近期舉辦環保設備制造項目的政府對接會。項目方專業生產環保設備,客戶遍布政府部門、教育系統、企事業單位。項目建成后將整合上下游產業,以環保裝備產業為基礎,以環保技術研發和環保產業服務總部為...
2020-11-08 VIEW MORE
東方龍商務將于近期舉辦鋁金屬配件制造項目的政府對接會。項目方長期生產各類金屬鑄件、鋁工業制品、相關壓延產品,具備良好的競爭優勢和穩定客戶。根據項目方公司發展計劃,將新建鋁金屬配件制造廠區以擴大現有產能...
2020-11-08 VIEW MORE
東方龍商務深圳分公司將于近期舉辦高分子新材料全國布點項目的政府對接會。項目方主要生產功能化學品和功能高分子材料,一直以世界化工巨頭為目標,以環保生活、優質服務為初衷,為客戶提供完善的低碳材料解決方案。...
2020-11-08 VIEW MORE
東方龍商務深圳分公司將于近期舉辦智能汽車電子項目的政府對接會。項目方主要生產汽車內部電子產品,同時擁有自己的車聯網平臺,經過長期的市場規劃和快速發展成為國內領先的汽車電子高科技企業。公司以安全愉悅的汽...
2020-11-08 VIEW MORE
東方龍商務將于近期舉辦汽車零部件項目的政府對接會。項目方主要生產汽車零部件和整車組裝配件,作為國內領先的汽車零部件輕量化高新企業,項目方以整車行業零部件體系為支撐,保持自主創新能力,成為具備相關配...
2020-11-08 VIEW MORE
東方龍商務將于近期舉辦高性能機械潤滑劑項目的政府對接會。項目方致力于通過亞洲、世界第三的核心技術,實現項目產品的國產化、規模化生產,打破國外壟斷局面。項目概況項目產品可實現嚴苛工況下的發動機潤滑和...
2020-11-08 VIEW MORE上海東方龍商務科技集團有限公司版權所有 滬ICP備17016133號-1 公安備案:31011402007031 免責聲明:網站部分內容來源于網絡,如有侵權,請聯系刪除!

掃一掃關注公眾號